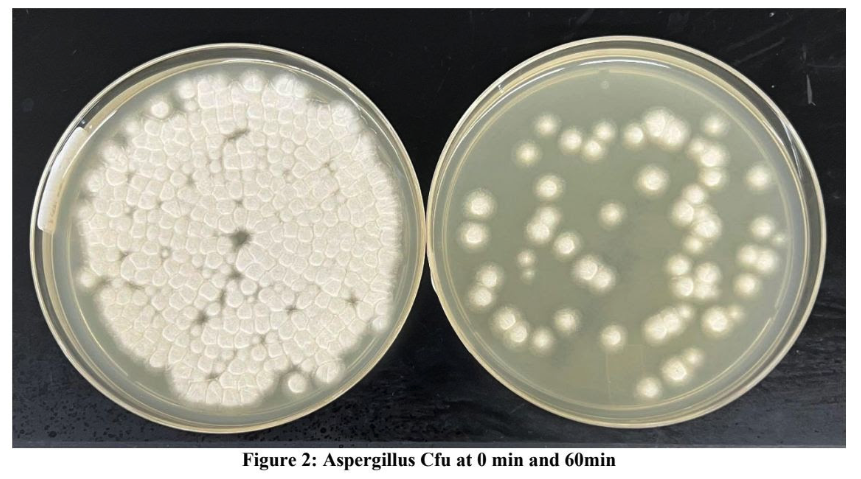
Laboratory petri dish comparison showing Aspergillus colony-forming units at 0 and 60 minutes during mold spore reduction testing.
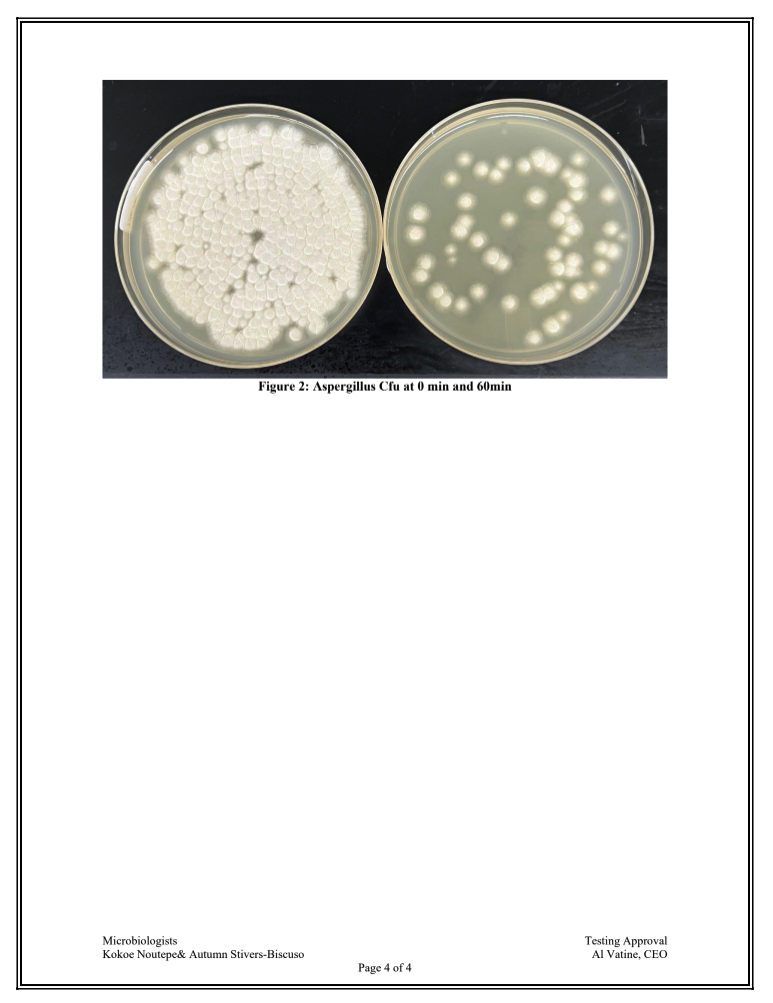
Laboratory petri dish comparison of Aspergillus colony-forming units at 0 and 60 minutes during LMS Technologies mold reduction testing.

JASPR vs Mold: What Third-Party Lab Testing Reveals About Airborne Mold Reduction
This article serves as an update to my full JASPR Air Purifier review.
This post focuses specifically on third-party laboratory testing that examined JASPR’s ability to reduce airborne mold spores.
Why Mold Spores Matter Indoors
Mold spores are present in virtually all indoor and outdoor environments. While complete elimination is unrealistic, elevated airborne concentrations may contribute to:
• Respiratory irritation
• Allergic responses
• Odor issues
• Indoor air quality degradation
In tightly sealed modern buildings, spores can accumulate without adequate ventilation or filtration. This makes air purification an important part of environmental management — though it does not replace remediation of active mold growth.
Here is a photo of a petri dish mold sample ONLY 60 minutes after running the Jaspr in a 500 square foot room. (Image Below)
Overview of the Third-Party Laboratory Study
A microbiology report conducted by LMS Technologies evaluated JASPR’s performance under controlled laboratory conditions.
Study Protocol
Researchers:
Saturated a sealed chamber with millions of mold spores
Activated the JASPR air purifier
Measured airborne mold concentrations over 60 minutes
Environmental conditions were standardized:
• Temperature: 72.9°F
• Humidity: 43.7%
• Sealed testing chamber
Air samples were collected at regular intervals using calibrated equipment to ensure accuracy and repeatability.
Laboratory Findings
After 60 minutes of operation:
JASPR reduced airborne mold spores by 87%.
Projected reductions based on sustained operation:
• ~98% reduction after 3 hours
• ~99.9% reduction after 24 hours
Repeated trials demonstrated consistent results under identical conditions.
It is important to clarify:
This testing evaluated airborne spores only — not mold embedded in walls, ceilings, or HVAC systems.
Considering JASPR for Mold-Related Air Concerns?
If reducing airborne mold spores is part of your indoor air strategy, the third-party lab results offer measurable insight into JASPR’s filtration performance under controlled conditions.
While no air purifier replaces proper mold remediation, consistent HEPA filtration may help lower airborne spore concentration when used in appropriately sized spaces.
You can explore JASPR’s specifications and current availability below.
Use JASPR discount code FRESH at checkout for 25% off your order.
How JASPR’s Filtration System Works
JASPR uses a three-stage filtration system:
• Pre-filter for larger particles
• True HEPA filter (captures 99.97% of particles down to 0.3 microns)
• Activated carbon for odor and VOC reduction
Mold spores typically range from 2–10 microns, meaning they fall within the capture range of HEPA filtration.
The laboratory results align with what would be expected from properly functioning HEPA-based air purification in a sealed environment.
What This Means for Real Homes
Laboratory environments differ from lived-in spaces.
In a real home:
• Doors open
• HVAC systems cycle
• Outdoor air infiltrates
• Mold sources may remain active
An air purifier can reduce airborne spores, but it does not:
• Kill mold inside walls
• Replace professional remediation
• Address moisture sources
It functions as a continuous airborne particle reduction tool.
Practical Implications
For households concerned about:
• Mold exposure history
• Musty odors
• High humidity environments
• Allergy-related sensitivity
A purifier that demonstrates measurable airborne spore reduction may serve as a supportive layer in a broader air quality strategy.
This includes:
• Dehumidification
• Mold remediation when necessary
• HVAC maintenance
• Proper ventilation
👉 See how JASPR performs in real-world mold and allergy-sensitive environments.
How JASPR Compares to General HEPA Filtration
The 87% reduction in 60 minutes is consistent with performance expected from high-efficiency HEPA-based systems operating in contained environments.
What differentiates JASPR in this context:
• Commercial-grade airflow
• Multi-stage filtration
• Steel housing durability
• Continuous operation design
However, it remains one tool among several for managing indoor environmental quality.
Final Assessment
The third-party laboratory testing provides measurable evidence that JASPR can significantly reduce airborne mold spores under controlled conditions.
It does not eliminate mold.
It does not replace remediation.
It does not guarantee health outcomes.
But it does demonstrate strong filtration performance when evaluated using standardized methods.
For those seeking an air purifier specifically to reduce airborne mold particles, these findings offer data-backed support for JASPR’s filtration capabilities.
If you’d like to explore JASPR further, you can review current specifications and availability below.
👉 Explore our 2026 air purifier comparison to see how JASPR compares to other leading models.
3rd Party Lab results via LMS Technologies:
Key Takeaways
• 87% reduction in airborne mold spores within 60 minutes
• Third-party lab validation
• HEPA filtration aligns with spore capture ranges
• Supports airborne reduction — not structural remediation
• Best used as part of a comprehensive indoor air strategy
Frequently Asked Questions About JASPR and Mold
Does JASPR eliminate mold in a home?
No. JASPR reduces airborne mold spores through HEPA filtration but does not remove mold growing in walls, ceilings, or hidden surfaces. Active mold issues require proper remediation.
How effective is JASPR at removing airborne mold spores?
In third-party laboratory testing, JASPR reduced airborne mold spores by 87% within 60 minutes under controlled conditions. Results in real homes may vary depending on room size and ventilation.
Can an air purifier prevent mold growth?
Air purifiers do not prevent mold growth. Mold develops due to moisture. However, reducing airborne spores may help lower overall indoor spore concentration when combined with humidity control.
Is HEPA filtration effective against mold spores?
Yes. Mold spores typically range from 2–10 microns in size, which falls within the capture range of properly functioning HEPA filters.
Is JASPR suitable for people sensitive to mold?
JASPR may help reduce airborne mold particles, which could improve indoor air quality in sensitive households. It is not a medical device and does not treat health conditions.
Looking to Improve Indoor Air Quality in a Mold-Conscious Home?
If mold exposure or high humidity environments are ongoing concerns, adding continuous HEPA filtration may be a practical layer within a broader air quality plan.
JASPR is designed for sustained operation and multi-stage filtration in everyday living spaces.
Explore pricing and filter details below.
Use JASPR discount code FRESH to receive 25% off your JASPR order.